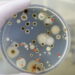
Estudo revela que fungo de “The Last of Us” pode se espalhar globalmente

Toronto, a maior cidade do Canadá, é conhecida por suas diversas atrações turísticas, entre elas o Path Toronto, uma vasta rede subterrânea que se estende por quilômetros sob o centro da cidade. Este complexo é mais do que uma simples passagem; é um mundo à parte, com lojas, restaurantes e acesso a diversos pontos turísticos. Para muitos brasileiros, a ideia de uma cidade subterrânea é intrigante, especialmente em um país tropical como o Brasil.
O Path Toronto não é apenas uma curiosidade arquitetônica, mas uma solução prática para o clima extremo da cidade. Durante o inverno, quando a neve cobre as ruas, e no verão, quando a umidade é alta, os túneis oferecem um refúgio confortável para os pedestres. Essa rede de caminhos conecta importantes edifícios e áreas de negócios, tornando-se essencial para a vida cotidiana em Toronto.
Como surgiu o Path Toronto?
A história do Path Toronto remonta ao início do século XX. Em 1900, a T. Eaton’s Co., uma famosa rede de lojas canadense, construiu os primeiros túneis para conectar sua loja principal a um anexo. Desde então, o sistema cresceu significativamente. Hoje, o Path possui 125 entradas e se estende por 30 km, sendo reconhecido pelo Guinness World Records como o maior complexo subterrâneo de compras do mundo.
O crescimento do Path foi acompanhado por melhorias na sinalização, facilitando a navegação pelos seus corredores. As setas coloridas no teto ajudam os visitantes a se orientarem, indicando as direções norte, sul, leste e oeste. Além disso, placas informam em que prédio o visitante está e para onde ele se dirige, tornando a experiência de explorar o Path mais intuitiva.
@tfaimmigration Você sabia que existem cidades subterrâneas no Canadá? Path (que significa caminho em português) é a cidade que fica no subsolo de Toronto e ocupa mais de 370 mil metros quadrados. Vem conhecer essa cidade dando PLAY no vídeo! #path #pathtoronto #torontopath #TFA #brasileirosemtoronto #toronto ♬ som original – Terry Ferreira & Associates
O que fazer no Path Toronto?
Com cerca de 1.200 pontos comerciais, o Path Toronto oferece uma variedade de opções para compras e lazer. Entre as lojas, destacam-se marcas conhecidas como Apple, Guess e Fossil. O Toronto Eaton Centre, um dos principais shoppings da cidade, está conectado ao Path, oferecendo uma experiência de compras completa.
Além das compras, o Path proporciona acesso a importantes pontos turísticos de Toronto. A CN Tower, o Ripley’s Aquarium of Canada e o Hockey Hall of Fame são apenas alguns dos locais que podem ser visitados a partir do Path. Para os amantes da cultura, o Entertainment District, com seus teatros e cinemas, também é facilmente acessível através dos túneis.
Por que visitar o Path Toronto?
Visitar o Path Toronto é uma experiência única que combina conveniência e entretenimento. Para os moradores, é uma parte essencial do dia a dia, enquanto para os turistas, oferece uma maneira diferente de explorar a cidade. A rede não apenas facilita o deslocamento, mas também proporciona uma visão fascinante da infraestrutura urbana dessa cidade.
Com sua mistura de lojas, restaurantes e acesso a atrações turísticas, o Path Toronto é um exemplo notável de como a arquitetura pode se adaptar às necessidades climáticas e urbanas de uma cidade. Para quem visita Toronto, explorar essa cidade subterrânea é uma oportunidade de descobrir um lado diferente e inovador da metrópole canadense.